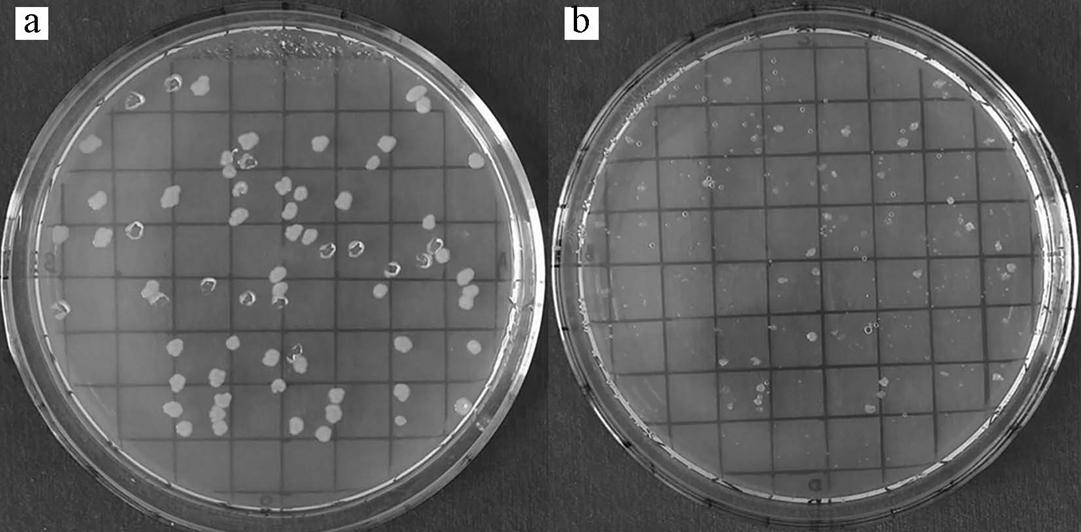

1 引言
目前,隨著現(xiàn)代工業(yè)的不斷發(fā)展,大量有毒有害廢水排入到環(huán)境中,苯酚作為樹脂制造、煉油、制藥、焦碳原料等工業(yè)過程中的重要工業(yè)原料和產生的一種有機污染物,是工業(yè)污水中的主要有害物質,會對動、植物產生有毒甚至致命的危害.苯酚對水生生物具有很強的毒害作用,水體中5~25 mg · L-1的濃度即可對魚類的生存構成威脅.長期飲用被苯酚污染的水或吸入低濃度酚蒸汽或會引起長期累積性中毒,而飲用高濃度酚溶液、吸入高濃度酚蒸汽則將引起急性中毒,尤其對人體神經系統(tǒng)危害較大.美國環(huán)保署把苯酚列入129種優(yōu)先污染物和65種有毒污染物之列,我國也把苯酚列入中國環(huán)境優(yōu)先處理的污染物“黑名單”之中.因此,去除水體中的苯酚等酚類污染物已成為污水處理的重要課題.
降解酚類的方法主要包括吸附法,電化學法和生物降解法等,其中生物降解因投資與運行成本低、二次污染小、處理效率高等優(yōu)點,因而廣泛應用于含酚廢水處理.近年來,許多學者在這方面進行了大量的研究,從被酚類物質污染的環(huán)境中已分離得到多種降解酚類的微生物菌株,主要有根瘤菌、酵母菌、醋酸鈣不動桿菌、假單胞菌、真養(yǎng)產堿菌、反硝化菌、紅球菌等.其中,大部分研究主要集中于酵母菌、芽孢桿菌以及假單胞桿菌,對Acinetobacter屬的細菌較少報道.生物降解法處理有毒和難降解的工業(yè)廢水時,一般需要利用生物強化技術來馴化、篩選、誘變和選育高效微生物降解利用有毒有害物質,但工業(yè)廢水組成成分的動態(tài)變化特點易對生物系統(tǒng)造成沖擊,使其中的高效降解微生物菌群致死、流失.利用高效降解微生物對苯酚進行生物降解,能有效去除水體中的苯酚,但降解過程的影響因素較多,有必要從諸多影響因素中篩選出最為重要的影響因素,控制生物降解系統(tǒng)能較好的耐受環(huán)境沖擊并高效運轉.由于傳統(tǒng)單因素實驗不能確定主次因素的差別,而Plackett-Burman實驗廣泛應用于生物過程重要參數(shù)的篩選,通過對實驗進行統(tǒng)計學設計和數(shù)據(jù)分析,篩選出對目標值影響最大的關鍵因素.響應面分析法(response surface methodology,RSM)是一種優(yōu)化過程的有效方法,其中的Box-Behnken實驗設計法比較常用,可用于確定實驗因素及其交互作用在過程中對指標響應值的影響,精確的表述因素與響應值之間的關系.該法與正交設計比較,所需實驗組數(shù)相對較少,更能直觀體現(xiàn)因變量的最佳值.
本研究從株洲某化工廠污水處理車間氧化池的活性污泥中篩選分離出一株能高效降解苯酚的細菌菌株YH8,根據(jù)其形體特征、生理生化性狀、BIOLOG鑒定、16S rDNA和gyrB序列分析進行分類鑒定,研究了該菌株降解苯酚的特性和初步探討了該菌株降解苯酚的途徑,并利用響應面法(RSM)優(yōu)化菌株YH8降解苯酚的條件以提高降解效率.
2 材料與方法
2.1 實驗材料
2.1.1 樣品來源
從株洲市某化工廠廢水處理車間氧化池采集的活性污泥作為篩選降解菌株的樣品.
2.1.2 培養(yǎng)基
種子培養(yǎng)基(LB):每升含酵母粉5 g,胰蛋白胨10 g,NaCl 10 g,pH 7.0~7.2.無機鹽培養(yǎng)基(MS):每升含K2HPO4 0.4 g、KH2PO4 0.4 g、NaCl 0.1 g、(NH4)2SO4 0.04 g、MgSO4 · 7H2O 0.1 g、MnSO4 · H2O 0.01 g、Fe2(SO4)3 · H2O 0.01 g、NaMoO4 · 2H2O 0.01 g,加水定容至1000 mL. 選擇培養(yǎng)基:在已滅菌的MS培養(yǎng)基中,按濃度要求加入經0.22 μm微孔濾膜過濾的苯酚母液(10 g · L-1水溶液),pH 7.0.以上固體培養(yǎng)基需加入1.8%的瓊脂粉,經121 ℃、20min高壓滅菌備用.
2.2 實驗方法
2.2.1 菌株的分離純化
準確稱量氧化池活性污泥10 g,加入到裝有90 mL三級水的錐形瓶中,30 ℃、200 r · min-1恒溫搖床中振蕩培養(yǎng)1 h.將重懸液按2%接種量加入到含苯酚的選擇培養(yǎng)基中,苯酚濃度按100、200、500、1000、1200、1500、2000 mg · L-1依次提高以梯度馴化與富集降解菌.經過多次轉接培養(yǎng),梯度稀釋培養(yǎng)液并涂布于含苯酚固體選擇培養(yǎng)基上,在30 ℃恒溫培養(yǎng)箱中倒置培養(yǎng)12 h.挑取菌落形態(tài)不同的單菌落接種至LB平板上,反復劃線分離純化得到純菌株,保存于4 ℃冰箱中備用.
2.2.2 降解菌的篩選
將保藏的純化菌株接種至LB平板上,劃線分離單菌落.挑取單菌落接種到LB液體培養(yǎng)基中,30 ℃、200 r · min-1振蕩培養(yǎng)至OD600為2.0(對數(shù)生長期末期).連續(xù)活化3代后,用生理鹽水將發(fā)酵液離心洗滌2次并重懸菌體.以2%接種量接種至選擇培養(yǎng)基中,振蕩培養(yǎng)并間隔12 h檢測培養(yǎng)液中苯酚含量,從中挑選降解苯酚能力最強的菌株.
2.2.3 形態(tài)特征鑒定
肉眼觀察降解菌的菌落形狀、大小、顏色、透明度、粘稠度、濕潤度、隆起和邊緣特征及是否產色素等,菌體染色后用高倍顯微鏡觀察菌體革蘭氏染色、鞭毛、莢膜、芽孢等結構,利用日立S-3400N型掃描電鏡觀察菌體大小和表面結構.
2.2.4 生理生化特性測定
參照文獻進行生理生化鑒定,另采用BIOLOG全自動鑒定儀比對代謝指紋進行鑒定.采用添加5 μg · mL-1的抗生素,濃度梯度為50、100、400、500、800、1000、1200、1500、2000 mg · L-1的重金屬鹽的LB培養(yǎng)基培養(yǎng)YH8,檢測菌株的相關抗性.
2.2.5 16S
rDNA基因序列的測定及分子系統(tǒng)發(fā)育樹的構建 細菌基因組DNA采用EasyPure Genomic DNA Kit試劑盒,依據(jù)說明書提取.16S rDNA基因序列的獲取參照文獻.PCR產物經瓊脂糖電泳檢測純化,送上海生工進行雙向測序并拼接輸出全序列,16S rDNA序列用BLAST進行相似性搜索和同源性比對,采用ClustalX 1.8進行序列匹配分析,通過MEGA6.0軟件使用鄰接法(Neighbor-Joining method)構建系統(tǒng)發(fā)育樹,利用Bootstrap(1000次重復)檢驗各分支的置信度.
2.2.6 gyrB基因序列的測定及分子系統(tǒng)發(fā)育樹的構建
gyrB基因是普遍存在于細菌中編碼促旋酶B亞單位的基因,該基因進化速率快,每100萬年的平均堿基替換率為0.7%~0.8%,gyrB基因彌補了非蛋白編碼基因16S rDNA無法區(qū)分近源種的缺陷.以提取的細菌基因組DNA為模板,采用gyrB的保守引物對UP-1F/UP-2R進行PCR擴增,PCR反應體系及反應步驟參照文獻.利用測序引物UP-1S:5′-GAAGTCATCATGACCGTTCTGCA-3′和UP-2sr: 5′-AGCAGGGTACGGATGTGCGAGCC-3′雙向測序并連接,gyrB序列構建系統(tǒng)發(fā)育樹的方法同上.
2.3 優(yōu)化降解條件
經單因素實驗確定影響YH8降解苯酚的環(huán)境因素.以苯酚降解率為響應值,采用三步法進行苯酚降解的優(yōu)化.首先,利用Plackett-Burman設計選出對菌株降解苯酚效率影響較大的因素,然后利用最陡爬坡設計逼近最佳區(qū)域,最后利用響應曲面法中的Box-Benhnken設計進行實驗.通過實驗數(shù)據(jù)擬合響應面模型,最終確定最優(yōu)降解條件并進行驗證.實驗數(shù)據(jù)借助SPSS和Design Expert軟件進行分析.
2.4 苯酚降解機理的研究
2.4.1 細胞粗酶液的提取
將篩選到的菌株YH8接種至選擇培養(yǎng)基(含1000 mg · L-1苯酚)和LB培養(yǎng)基中,30 ℃、200 r · min-1振蕩培養(yǎng)32h,取對數(shù)生長期末期菌液50 mL,4 ℃、12000 r · min-1離心10 min,上清液即為胞外粗酶液,于-20 ℃凍存.菌體沉淀用pH 7.0的磷酸緩沖液清洗兩次后,重懸于磷酸緩沖液中.在冰浴中,用HUP-400A型超聲波細胞破碎儀破碎細胞,超聲破碎30 s,間隔30 s,連續(xù)處理10 min.于4 ℃、13000 r · min-1離心20 min,上清液即為胞內粗酶液,于-20 ℃凍存.
2.4.2 菌株降解苯酚相關基因的PCR擴增
以細菌基因組DNA為模板,擴增苯酚羥化酶(LmPH)、鄰苯二酚2,3-雙加氧酶(C23O)和鄰苯二酚1,2-雙加氧酶(C12O)基因片段.LmPH引物為Lph:5′-AGGCATCAAGATCACCGACTG-3′;Lph2:5′-CGCCAGAACCATTTATCGATC-3′. C23O引物為C23OF:5′-GGTCTGATYGAAATGGAYCGCGA-3′;C23OR:5′-CGTTCGTTSAGCACCCGGTCGTG-3′. C12O引物為C12OF:5′-CCTGARCBGTHGGYTTT GCNCGTATGGATGA-3′;C12OR: 5′-TCACGRGTW GCRWARGCAAAGTC-3′.上述基因片段擴增體系與16S rDNA基因序列擴增體系相同,LmPH引物的PCR反應程序為:94 ℃預變性5min;94 ℃變性30s,52 ℃退火30s,72 ℃延伸1min,30個循環(huán);72 ℃延伸10min.C12O和C23O的引物的PCR反應程序為:94 ℃預變性3min;94 ℃變性30s,59 ℃退火30s,72 ℃延伸1min,30個循環(huán);72 ℃延伸10min.PCR產物經瓊脂糖電泳檢測、純化、測序,測序結果用BLAST軟件與Genbank數(shù)據(jù)庫中已收錄的基因序列進行同源性比對.
2.4.3 質粒的檢測與消除
采用堿裂解法抽提質粒.質粒消除采用變溫-SDS法.采用點接法將單菌落按相同位置接種至LB和選擇培養(yǎng)基的平板上,對能在LB平板上生長而不能在選擇培養(yǎng)基上生長的菌株進行質粒檢測.挑取質粒消除突變菌株利用LmPH和C12O引物進行PCR擴增,檢測突變菌株是否存在LmPH和C12O基因.
2.5 分析方法
2.5.1 細胞濃度的測定
采用可見分光光度法在600 nm下測定培養(yǎng)液的吸光度(OD600).
2.5.2 苯酚濃度的測定
采用4-氨基安替比林直接分光光度法測定苯酚的含量.
2.5.3 粗酶液活性測定
苯酚羥化酶活性的測定參照文獻.分別參考文獻檢測鄰苯二酚1,2-雙加氧酶(C12O)和鄰苯二酚2,3-雙加氧酶(C23O)催化降解鄰苯二酚的產物粘糠酸和2-羥基粘糠酸半醛,分別在260 nm和375 nm處有最大吸收峰.C12O和C23O酶活力測定以單位時間內反應產物分別在260 nm和375 nm處吸光度變化表示.反應體系為8.01 mL鄰苯二酚、0.39 mL磷酸緩沖液(pH=7.0)和0.6 mL粗酶液,以緩沖液為參比.定義C12O(或C23O)活力單位(U)為25 ℃條件下每分鐘反應產生1 μmol產物所需酶量.總蛋白含量用Bradford法測定,具體方法參見全式金Easy Protein Quantitative Kit試劑盒說明書.酶的比活力以每毫克的蛋白質中所含酶的活力單位數(shù)計算.
3 結果與討論
3.1 菌株的分離與純化
從活性污泥中分離純化得到單菌落,劃線分離后獲得58株苯酚降解菌.通過復篩得到一株苯酚降解能力最強的菌株,命名為YH8.在馴化前,菌株YH8在苯酚濃度為1000 mg · L-1的選擇培養(yǎng)基中,經30 ℃、200 r · min-1培養(yǎng)2d可使苯酚降解率達到78.54%.采用梯度濃度馴化后,菌株YH8可在4d內使1200 mg · L-1的苯酚降解89.47%.
3.2 菌株的鑒定
3.2.1 形態(tài)特征鑒定
菌株YH8的菌落呈圓形、淺白色、中間隆起、邊緣整齊、濕潤有光澤、較透明、較粘稠、不產色素.菌株細胞呈短桿狀,有莢膜,無鞭毛與芽孢.經掃描電鏡觀察該菌在LB和選擇培養(yǎng)基生長的菌株細胞差異,正常細胞表面較光滑,而苯酚則使該菌細胞表面出現(xiàn)凹陷(圖 1~圖 2).因苯酚在水溶液水解成酸性,高濃度的苯酚對細胞有一定的毒害作用,故選擇培養(yǎng)基中培養(yǎng)的細胞易出現(xiàn)破損等現(xiàn)象.

圖1 YH8在LB中的掃描電鏡圖(×20.0 k)
圖2 YH8在苯酚中的掃描電鏡圖(×20.0 k)
3.2.2 生理生化鑒定
菌株YH8生理生化指標如下:革蘭氏染色陰性、氧化酶陰性、過氧化氫酶陽性、苯丙氨酸脫氨酶陰性、吲哚實驗陰性、淀粉水解陰性、硫化氫陰性、三糖鐵陰性、硝酸鹽還原陽性、V-P實驗陰性、甲基紅陰性、明膠液化陽性、纖維素酶陰性,4 ℃可生長,40 ℃不能生長,不具有運動性.將菌株YH8細胞懸浮液接種至BIOLOG GN2板微孔中,培養(yǎng)4h和16h后分別測定菌株代謝指數(shù).經BIOLOG細菌鑒定系統(tǒng)分析,菌株YH8代謝指數(shù)與Acinetobacter guillouiae(Acinetobacter genospecies 11)的相似性為94%.
重金屬抗性實驗發(fā)現(xiàn),菌株YH8能在分別添加1.0 g · L-1 Pb2+、1.5 g · L-1 Cr6+、1.8 g · L-1 Cr3+、0.5 g · L-1 Cd2+、1.0 g · L-1 Sb3+、3.0 g · L-1 Mn2+、1.0 g · L-1 Cu2+和1.0 g · L-1 Zn2+的LB培養(yǎng)基中正常生長,低于1 g · L-1的Cr3+、Mn2+、Zn2+可促進菌株的生長,而Cd2+、Hg2+、Ag+對菌株的生長有強烈的抑制作用.同樣,龔斌從含有一定濃度的Cd2+、Pb2+、Mn2+、Ni2+的酚類廢水中篩選到一株具有重金屬抗性的假單胞菌JF-10,可用于重金屬污染水體的苯酚污染生物修復.藥敏實驗結果表明菌株YH8能耐受5 μ g · mL-1的氯霉素、氨芐青霉素、卡那霉素、紅霉素,而對四環(huán)素、慶大霉素、壯觀霉素、頭孢噻肟鈉和利發(fā)霉素敏感.菌株在NaCl濃度為1%~12%的選擇培養(yǎng)基中生長,表明菌株YH8可適應較高滲透壓的環(huán)境.
3.2.3 分子生物學鑒定
菌株YH8的16S rDNA經PCR擴增得到一條約1.5Kb的DNA片段,測序得到1448bp的序列,其GenBank登錄
號為KM658327.16S rDNA序列BLAST結果表明,菌株YH8與Acinetobacter guillouiae和Acinetobacter lwoffi的16S rDNA序列具有極高的同源性(99%).構建的16S rDNA序列系統(tǒng)發(fā)育樹(圖 3)表明菌株YH8與多株不動桿菌處在同一個分支.

圖3 菌株YH8的16S rDNA基因系統(tǒng)發(fā)育樹
經PCR擴增獲得一段約1.3 kb的DNA片段,測序得到1182bp的序列,其GenBank登錄號為KM658329.gyrB序列BLAST結果表明,菌株YH8與Acinetobacter baylyi的gyrB序列具有很高的同源性(98%),而與其它菌株gyrB基因相似性均在98%以下,系統(tǒng)發(fā)育分析(圖 4)表明,菌株YH8與Acinetobacter baylyi同處在一分支.因NCBI數(shù)據(jù)庫中暫未收錄Acinetobacter guillouiae的gyrB序列數(shù)據(jù),故gyrB基因系統(tǒng)進化樹中與YH8同一分支中未出現(xiàn)Acinetobacter guillouiae.綜合16S rDNA和gyrB基因序列分析以及菌株形態(tài)和生理生化特征,菌株YH8鑒定為Acinetobacter guillouiae.
圖4 菌株YH8的gyrB基因系統(tǒng)發(fā)育樹
3.3 苯酚代謝途徑及相關降解酶特性測定
3.3.1 降解酶基因擴增
按試劑盒說明從菌株YH8中提取到基因組DNA.分別利用LmPH(Lph1/Lph2)、C12O(C12OF/ C12OR)、C23O(C23OF/ C23OR)引物對菌株YH8的基因組DNA進行PCR擴增,結果發(fā)現(xiàn)引物LmPH、C12O有明顯的擴增產物(圖 5),而C23O引物無明顯的擴增產物.將擴增產物測序,獲得LmPH基因大小為691 bp的片段,C12O基因大小為359 bp的片段.測序比對結果表明,菌株YH8的LmPH基因序列與登錄號為D85083.1的LmPH序列同源性最高,達到97%;該菌株的C12O序列與登錄號為Z36909.1的C12O序列同源性最高,達到96%.故證明菌株YH8基因組中包括LmPH和C12O基因.苯酚代謝途徑的限速步驟由第一步的苯酚羥化酶的催化決定,自然環(huán)境中有單組分和多組分兩種苯酚羥化酶,而多組分苯酚羥化酶是自然環(huán)境的優(yōu)勢類型(El-Sayed et al., 2014).(譚東徽等,2010)通過染色體步移技術克隆得到 總長約為6 kb的苯酚羥化酶基因,其中ORF4(開放閱讀框)編碼苯酚羥化酶大亞基,與編碼產堿桿菌(Alcaligenes sp.)苯酚羥化酶大亞基基因的同源性達到93%,為構建高效基因工程菌提供了一定的理論基礎.

圖5 苯酚羥化酶基因片段和鄰苯二酚1,2雙加氧酶基因片段的擴增產物
3.3.2 降解酶活性測定
通過測定菌株YH8粗酶液中LmPH、C12O和C23O的活性,初步判斷該菌株YH8降解苯酚的代謝途徑.菌株YH8粗酶活性檢測(表 1)表明,菌株YH8在LmPH的催化作用將苯酚轉化為鄰苯二酚,鄰苯二酚在C12O的作用下通過鄰位開環(huán)裂解途徑降解.這與運用氣質聯(lián)用儀分析生物滴濾塔處理后的苯酚氣體檢測到的結果一致,推測苯酚的轉化形式也相同.菌體破碎后上清液中LmPH和C12O的活性遠高于未破碎菌體上清液中酶活性,由此可見該酶為胞內酶.以LB培養(yǎng)基為基質的兩種上清液均未檢測到酶活,而選擇培養(yǎng)基中酶活遠大于LB培養(yǎng)基中酶活,說明該菌株LmPH和C12O為誘導酶.在研究四溴雙酚A(TBBPA)的微生物降解特性時,降解TBBPA的菌株H粗酶液中同樣檢測到一條明顯區(qū)別于純培養(yǎng)菌株的蛋白條帶,證明紅球菌株H相關降解酶是受TBBP誘導的特異性降解酶.

表1 不同基質中苯酚相關降解酶比活力
3.3.3 質粒檢測和消除結果
采用全式金transgen Plasmid MiniPrep Kit試劑盒抽提菌株細胞中的質粒,1%瓊脂糖凝膠電泳檢測出現(xiàn)3條目的條帶,說明菌株YH8具有一個5 kb左右的質粒.經變溫-SDS法消除質粒后,通過點解法得到只能在LB平板上生長而不能在僅含濃度為1000 mg · L-1 苯酚的MS培養(yǎng)基平板上生長的菌株(圖 6),質粒消除率可達57.73%.經質粒檢測,在質粒消除后的突變菌株中未發(fā)現(xiàn)質粒.挑取質粒消除突變菌株培養(yǎng)并經PCR擴增檢測,無LmPH和C12O基因擴增條帶出現(xiàn)(圖 7).這說明經質粒消除后的菌株不能利用苯酚作為唯一碳源生長,且可初步判定苯酚相關降解基因位于質粒上.結果與對不動桿菌質粒及其特性的研究結果一致.
圖6 LB(a)與苯酚(b)影印對照

圖7 質粒消除前后LmPH和C12O基因擴增結果(a. LmPH,b. C12O)
3.4 菌株YH8生長及對苯酚降解的影響
3.4.2 菌株YH8利用苯酚生長和降解苯酚曲線
將菌株YH8接種于含1000 mg · L-1 苯酚的MS培養(yǎng)基中,30 ℃、200 r · min-1搖床培養(yǎng),定時取樣測定菌體生長量及選擇培養(yǎng)基中的苯酚濃度.結果如圖 8所示,YH8菌株的生長同步于對苯酚的降解,且菌株的生長和降解曲線的遲緩期為0~12 h,這一時間段為菌株YH8細胞合成苯酚相關降解酶的誘導期.菌株在12~96 h進入對數(shù)期,大約在 96 h最大菌體生長量達到0.71,此時苯酚降解率達到94.52%.

圖8 菌株YH8利用苯酚生長和降解苯酚曲線
3.4.3 環(huán)境因素對菌株YH8生長和降解苯酚的影響
為了研究不同環(huán)境條件下菌株YH8對苯酚的降解情況,選擇苯酚濃度、溫度、接種量、初始pH、外加碳源、外加氮源5個影響因素作為研究對象,進行單因素實驗.實驗結果表明菌株YH8在苯酚濃度為1000~1200 mg · L-1時具有較高的降解率,高于1200 mg · L-1時,OD600值和苯酚降解率隨苯酚濃度增加而迅速減小.菌株YH8生長和降解苯酚的適宜溫度范圍為24~32 ℃,在30 ℃時菌株生長量和降解率達到最大,即30 ℃初步確定為最適溫度.菌株YH8生長和降解的臨界溫度為36 ℃,超過該溫度,菌株YH8的生長和代謝便基本停止.菌株的最適接種量為5%,而菌株YH8在pH為9.0對苯酚的降解率達到最高.添加山梨醇和NaNO3作為最適外加碳源和外加氮源可有效提高菌體的生長速度和降解率,而王玉芬等(2011)研究發(fā)現(xiàn)球形紅球菌只有在外加碳源的存在下才能降解氯代苯,而且不同碳源對氯代苯降解的影響變化較大,以蘋果酸和乙酸做碳源時的降解效果最好,這可能與球形紅球菌在好氧條件下必須通過共代謝才能降解氯代苯有關.
3.5 菌株YH8降解苯酚條件的優(yōu)化
3.5.1 PB實驗設計及結果
采用N=12 Placket-Burman 實驗設計研究菌株YH8對苯酚的降解率產生影響的7個因素,每組實驗重復3次.11個考察因素及其編碼水平見表 2,其實驗設計以苯酚降解率為響應值,借助實驗設計軟件Design Expert 7.1進行數(shù)據(jù)分析,其結果如表 3所示.通過比較各因素的顯著性水平,篩選出對苯酚降解率影響較為顯著的因素.

表2 Placket-Burman設計各因素與水平
從表 3可以看出,實驗組5的苯酚降解率最高,達96.68%;實驗組9的苯酚降解率最低,為35.78%.將實驗數(shù)據(jù)采用SPSS V19.0擬合后,可得方程為:
Y= 71.02-9.87X2-0.91X3+6.33X5+9.56X6+10.23X8+1.44X9-1.69X10
式中,X2為苯酚濃度(mg · L-1);X3為接種量(%);X5為NaNO3濃度(%);X6為山梨醇濃度(%);X8為初始pH;X9為溫度(℃);X10為培養(yǎng)時間(h);X1、X4、X7、X11為空白變量.

表3 Placket-Burman實驗設計與結果
應用Design Expert軟件分析得到模型的p為0.0396,表明所得回歸方程較顯著,即該模型在被研究的整個回歸區(qū)域擬合性較好.復系數(shù)R2=0.9244,說明相關性較好.校正決定系數(shù)Adj R2=0.7921,表明79.21%的實驗數(shù)據(jù)的變異性可用此回歸模型來解釋.通常情況下變化系數(shù)(Cv)越低,實驗的可信度和精確度越高,Cv值等于12.85%,表示PB實驗的可信度和精確度較好.精密度(Adeq Precision)是有效信號和噪聲的比值,大于4.0視為合理,本實驗精密度達到9.663.根據(jù)回歸分析結果(見表 4),從表 4可知苯酚濃度、山梨醇濃度以及初始pH對苯酚降解率存在顯著影響,其中初始pH的p值最小(p=0.0178),對菌株YH8降解苯酚效率影響最顯著,其次是苯酚濃度(p=0.0200),再次為山梨醇濃度(p=0.0222).其他4個因素,蔗糖濃度,苯酚濃度,溫度,培養(yǎng)時間p值均大于0.05,對苯酚降解率沒有明顯影響.由此,初始pH、苯酚濃度和山梨醇濃度為影響苯酚降解率的關鍵因素.

表4 Placket-Burman實驗分析結果
3.5.2 最陡爬坡實驗設計與分析
響應面擬合方程只有考察臨近區(qū)域時才能充分近似真實情況,所以應先逼近最大苯酚降解率區(qū)域后再建立有效的擬合方程.
根據(jù)Placket-Burman 實驗篩選出的3個顯著因素估計系數(shù)的正負效應,依次增大或減小,其他因素根據(jù)估計系數(shù)的正負效應分別取PB設計中的最高值和最低值.初始pH和胰蛋白胨濃度對苯酚降解率有顯著正效應,應依次增加.而接種量是負效應,應依次減少.其他因素的取值為接種量5%、NaNO3濃度2%、溫度30 ℃、培養(yǎng)時間96 h.由表 5數(shù)據(jù)分析可知,隨著初始pH和山梨醇濃度的增加及苯酚濃度的減小,苯酚降解率呈先增大后減小的趨勢.當初始pH為9.0,苯酚濃度為1100 mg · L-1,山梨醇濃度為5%時,苯酚降解率達到最大.因此,序號5的實驗為最大響應值區(qū)域,故以此為中心點進行響應面分析.

表5 最陡爬坡實驗設計及實驗結果分析
3.5.3 響應面分析法確定最佳降解條件
響應面分析法是一種尋找多因子系統(tǒng)中最佳條件的數(shù)學統(tǒng)計方法,其中Box-Behnken和Box-Wilson中心組合設計是兩種較常見的響應面分析法(RSA).通過爬坡路徑法確定降解條件重要影響因子范圍后,以初始pH、苯酚濃度和山梨醇濃度3種因子為自變量,以苯酚降解率為響應值,設計了3因素3水平的響應面分析試驗.第13~15次實驗為3次重復的中心點實驗,用于考察模型的誤差.實驗設計及結果見表 6.
運用Design Expert 軟件對15個實驗點的響應面值進行回歸分析,得二次多項式方程:
Y= 98.51-8.04A+6.15B+1.96C+2.89AB+1.82AC+5.80BC-7.45A2-10.07B2-10.80C2
式中,Y為苯酚降解率;A、B、C分別為初始pH、苯酚濃度、山梨醇濃度的編碼值.相關系數(shù)R2=0.9972,說明方程的擬合度很好,可以用該方程進行試驗結果預測.

表6 Box-Behnken 實驗設計及結果
預測模型的p值遠小于0.0001,說明該模型極顯著.結合響應面分析三維圖(圖 9),可直觀的看出各因素之間的交互作用,各實驗各因素對苯酚降解率的影響不是簡單的線性關系,且對響應值的影響存在一極值點.

圖9 菌株YH9各因素及其交互作用的響應面圖
根據(jù)表 7方差分析數(shù)據(jù)可知,表明對苯酚降解率的影響排序為:初始pH(X2)﹥苯酚濃度(X6)﹥山梨醇濃度(X8).其中,X2、X6、X8、X2X6、X6X8、X22、X26、X28對Y的影響差異極顯著,X2X8對Y的影響高度顯著.失擬項數(shù)值為0.4185,遠大于0.05,說明失擬不顯著,該模型穩(wěn)定,可以作為不同因素水平對苯酚降解率影響的預測.
根據(jù)模型構建的方程進行偏導微分處理,求導得出方程組的3個解:A=9.26,B=1163.63,C=7.81,即:初始pH 9.26、苯酚濃度1163.63 mg · L-1、山梨醇濃度7.81%.此時,YH8菌株對苯酚降解率的最大預測值為99.37%.

表7 Box-Behnken 實驗回歸分析結果
3.5.4 驗證試驗
為了驗證模型預測的準確性和有效性,按照優(yōu)化后的苯酚降解條件進行3組平行實驗,實際檢測苯酚的降解率達到98.95%,實驗值與預測值之間具有良好的擬合性,表明回歸方程能夠比較真實的預測各因素對菌株YH8降解苯酚的影響.降解優(yōu)化實驗組與未優(yōu)化實驗組的結果比較發(fā)現(xiàn),優(yōu)化后的最佳降解條件可使菌株YH8對苯酚的降解率提高7%左右.等利用響應面法優(yōu)化實驗設計,研究了酵母浸出物、苯酚濃度、接種量3個因素對菌株Candida tropicalis Z-04降解高濃度苯酚效果的影響,擬合多元二次回歸方程,并得到最佳降解條件下的實際降解率與預測值高度接近,說明響應面法能有效預測并優(yōu)化菌株對目標化合物的降解.具體參見污水寶商城資料或http://www.dongaorq.cn更多相關技術文檔。
4 結論
1)本研究從株洲某化工廠污水處理車間的污泥樣品中分離得到一株苯酚降解菌,經形態(tài)特征、生理生化、BIOLOG微生物全自動鑒定儀和16S rDNA序列分析,該菌鑒定為Acinetobacter guillouiae,命名為YH8.該菌株能利用苯酚為唯一碳源和能源生長,30 ℃、200 r · min-1培養(yǎng)96 h可使初始濃度為1200 mg · L-1的苯酚降解率達到92.65%.
2)在以苯酚為碳源和能源的培養(yǎng)基中,檢測到了與苯酚降解相關的主要酶活性-苯酚羥化酶和鄰苯二酚1,2-雙加氧酶,證明菌株YH8主要通過鄰位開環(huán)裂解途徑降解苯酚.對菌株YH8的相關降解酶研究表明,菌株YH8的相關降解酶位于胞內,只有誘導后菌體才能產生鄰苯二酚1,2-雙加氧酶的活性.利用特異引物進行PCR擴增可從菌株YH8基因組中擴增出一條251 bp的片段,測序比對結果顯示該片段為鄰苯二酚1,2-雙加氧酶基因片段.
3)通過質粒檢測和消除發(fā)現(xiàn)菌株YH8具有一個5 kb左右的質粒,且菌株YH8對苯酚的降解與質粒有關.此外菌株YH8可耐受多種重金屬和高濃度NaCl的存在.
4)采用Placket-Burman實驗設計篩選出影響菌株YH8降解苯酚的主要因素為初始pH、苯酚濃度和山梨醇濃度.應用響應面法分析優(yōu)化設計苯酚降解的最佳條件為:初始pH 9.26、苯酚濃度1163.63 mg · L-1、山梨醇濃度7.81%、接種量5%、NaNO3濃度2%、溫度30 ℃、培養(yǎng)時間96 h,在此條件下苯酚降解率可達98.95%.


